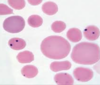
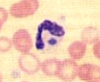

chlamydia is what type of bacteria?
obligate intracellular bacteria
(Chlamydia, coxiella, Richettsiales)
what drug for chlamydia
tetracycline
(Chlamydia, coxiella, Richettsiales)
chlamydia are unable to make ___
ATP
uses host machinery
(Chlamydia, coxiella, Richettsiales)
____ forms of chlamydia have virtually NO biochemical activity
Extracellular
(Chlamydia, coxiella, Richettsiales)
cell wall of chlamydia
gram - like
A cysteine-rich protein layer NOT thought to contain peptidoglycan.
(Chlamydia, coxiella, Richettsiales)
What is the chlamydia anomaly?
- sensitive to penicillin which attacks peptidogylcan
- they have the genes to make peptidogylcan- used for divison instead
- have cysteine rich protein layer instead
(Chlamydia, coxiella, Richettsiales)
life cycle of chlamydia

elemental bodies are the —- form of chlamydia
infectious and metabolically inactive
—- are the infectious and metabolically inactive form of chlamydia
elemental body
chlaymdia elementary bodies are taken up by — cells via —
epithelial cells
endocytosis (heparin receptor)
EBs turn into —
reticulate bodies - non infectious form and develops once ATP is available
chlamydia
— are the non-infectious form of chlamydia that develop once — is available
reticulate body
ATP
found inside epithelial cells
reticular bodies undergo — to generate more RBs
binary fission
how does chlaymdia get out of the cell
RB regress into EBs
cell is lysed
EBs are released
cycle repeats
chlamydia infect what type of cells
epithelial cells
chlamydia
the — is metabolically inactive, but infectious
the — is metabolically active, but not infectious
elementary body
reticulate body
tetracycline in young animals cause
doxycycline → enamel hypoplasia
fluoroquinolones cause — in young animals
joint issues (cartilage defects)
chlamydia psittaci is also called — in humans
and —- in animals
psittacosis
parrot fever
Chlamydia psittaci can be spread by —
Transmission often by inhalation of
litter/feces’
EB in the epithelial cells of the GI tract are sloughed off in feces
clinical signs of Chlamydia psittaci
Clinical signs in birds: conjunctivitis, respiratory, unkempt, yellow-green droppings, innappetance, weight loss
what type of chamydia effect koala
chlamydia pneumoniae
Dirty Tail
Dirty tail is caused by — and presents with —
chlamydia pneumoniae
Koala
UTI, incontinence, blindness, URI, infertility
transmitted by respiratory and sexually
what are the two biovar of chlamydia pneumoniae
koala → dirty tail→ UTI, URI, infertility and blindness
Equine → URI